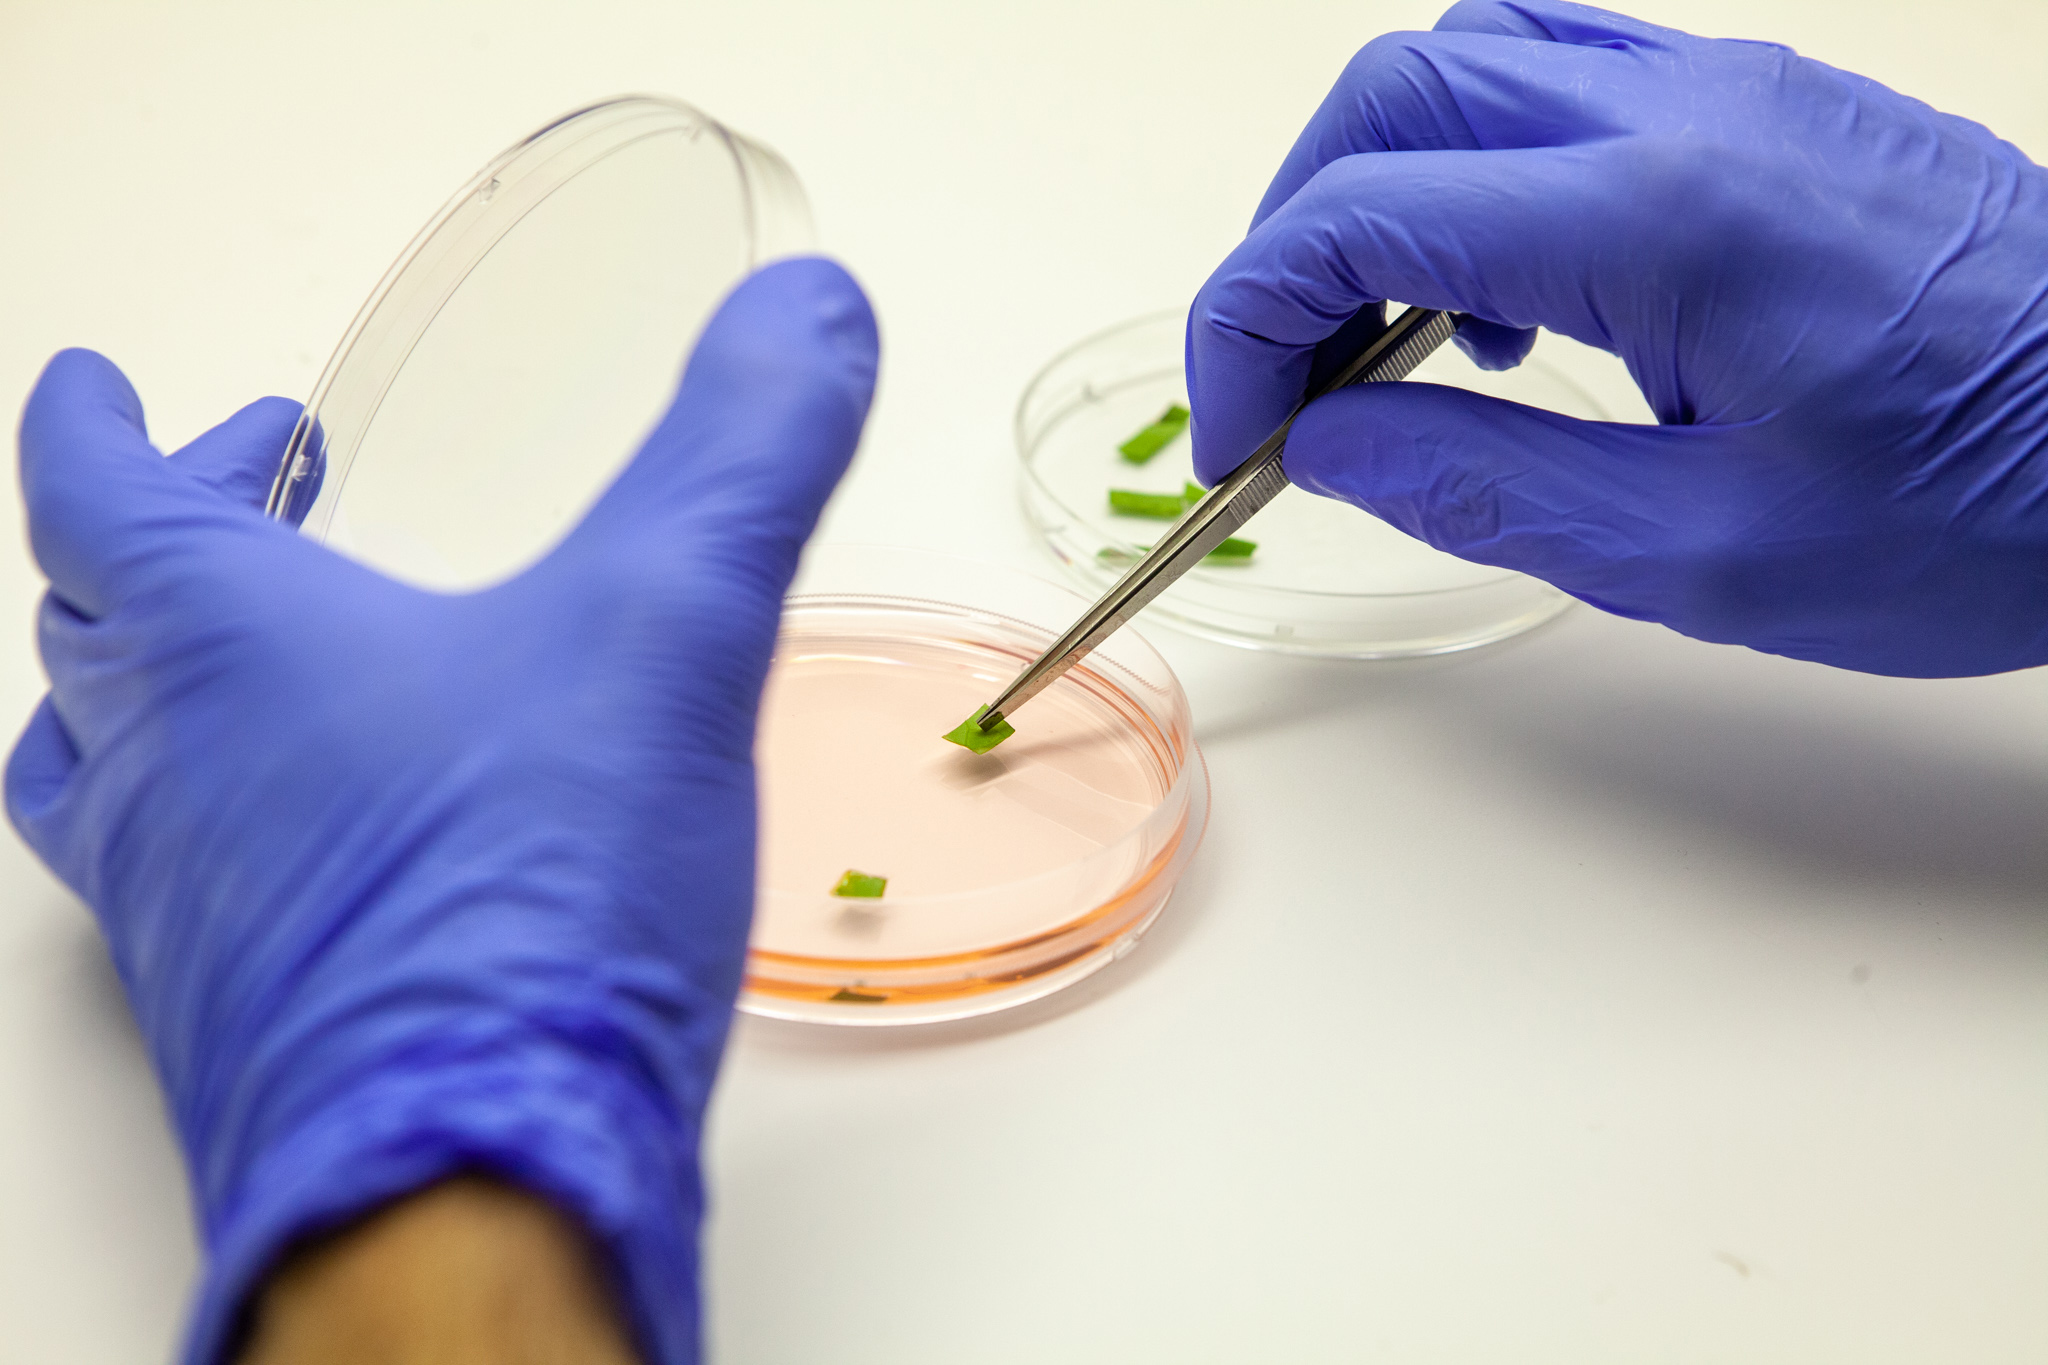

Ones to Watch: Strength in Numbers
Following a successful collaborative industry event, Louise Davis speaks with the event organizers and the 14 participating startups to hear how their united efforts are helping to determine the future of biomass fermentation
One of the key subjects covered throughout the pages of this publication is the vital importance of collaboration. We regularly report on cross-industry partnerships, governmental and regulatory alliances, funding partnerships, R&D collaborations, and other innovative ways that individual players in the broader alternative proteins sector can join forces for the greater good.
Recently, we witnessed a compelling demonstration of the tangible commercial benefits of collaboration at the MISTA Growth Hack, an industry event held last November. This unique gathering brought together some of the brightest minds in biomass fermentation and was hosted by MISTA, the innovation ecosystem created by food flavors expert Givaudan.
Explaining the event’s purpose, Céline Schiff-Deb, MISTA’s Chief Scientific Officer, states, “The Growth Hack involved two hack weeks focused on prototyping – one at MISTA in San Francisco and another at Givaudan’s Zurich Innovation Center. It also featured a Technical Symposium, followed by a Demo Day where participants pitched and showcased their innovations through tastings. This hands-on program is designed to accelerate the growth of startups and drive the evolution of the food system by fostering collaboration with leading food companies.” The primary objective of the program was to engage the entire MISTA ecosystem – including corporate members such as Givaudan, Ingredion, AAK, Danone, CJ Cheiljedang, Bühler Group, SIG, and JPG Resources, plus the startups – to explore and advance biomass fermentation’s role in the food system.
Schiff-Deb reveals that the event culminated with the development of approximately 30 food and beverage product concepts (some complete with designed packaging), centered around the unique ingredients from 14 pre-selected startups. “This led to a wealth of technical learnings for the large corporations and the startups, as well as for the 200 people who participated in our Demo Day and tasting,” she explains.
Focus on fermentation
The Growth Hack is an annual event, so why did MISTA choose biomass fermentation as the 2024 theme? “We are bullish about biomass fermentation as we see this technology as a major unlock to provide scalable and affordable nutrition in the near term, without putting extreme pressure on the environment,” Schiff-Deb responds. “As the microorganisms can be cultivated anywhere in controlled fermenters and fed simple nutrients, biomass fermentation can deliver predictable ingredient supplies (not impacted by weather, animal disease epidemics or world conflicts) with good sustainability attributes (often low use of arable land and water and reduced carbon footprint versus animal-derived counterparts) at economically viable costs.”
Schiff-Deb highlights that these ingredients offer high nutritional density and are free from contaminants such as pesticides, hormones, allergens, and anti-nutritional factors. “Fermenter production enables localized food systems,” she adds. “In some cases, upcycled food and agricultural sidestreams can replace sugar as feedstock, while certain microbes can use CO₂ or methane as carbon sources, decoupling food production from traditional agriculture.”
Collaborative effort
Each startup in the 2024 cohort brought something different to the table. Over the following 11 pages, we’ve profiled all 14 of the participants and the overall message from both them and MISTA is clear: there is power in unity, and in the alt proteins industry, collaboration is critical for success. This is particularly true given the backdrop to the Growth Hack, an event that took place on US soil during a period of enormous – and extremely divisive – political upheaval. Whether considering politics or alternative proteins, the phrase ‘united we stand, divided we fall’ has never been truer.

Making a splash
New Zealand startup, Nutrition from Water (NXW), only joined the MISTA ecosystem a few months before the symposium itself last November. According to Alex Worker, Founder & Director, its inaugural Growth Hack couldn’t have gone better. “We absolutely loved the event,” he enthuses. “It was a three-month working relationship (at first online, then in person at MISTA) that culminated in a week at MISTA San Francisco and a showcase of our Marine Whey-derived, affordable nutrition solutions.”

Worker explains that, in partnership with experts from SIG, Danone, Ingredion, AAK and Givaudan, “We showcased a delicious UHT mango lassi concept developed for everyday Indian families with 10g of Marine Whey, and a French vanilla ice cream concept showcasing Marine Whey emulsion performance for Brazilian/Colombian FMCG and food-service channels.”
And for NXW, the event immediately delivered tangible benefits. “Thanks to the Growth Hack, we are now exploring a couple of joint development agreements (JDAs) with multinational strategic partners, and have ongoing solutions co-development offers from Givaudan, SIG, as well as member companies from the wider MISTA network,” Worker reveals.
Magnificent microalgae
It’s perhaps unsurprising that showcasing its work in this way has led to significant developments for NXW, as the potential of its technology is evident. By demonstrating its capabilities and applications, the company has attracted attention from key industry players. Describing the firm’s approach, Worker explains, “We take a dairy nutrition-processing lens to developing natural, complete, non-GMO nutrition biotechnology from microscopic algae. NXW has exclusive access to the Pacific Ocean’s largest strain library of microalgae, managed by New Zealand’s Cawthron Institute.
“We are developing our first wave of nutrition products, including Marine Whey 50 (50%+ protein concentrate), for B2B nutrition leaders expanding affordable solutions in the Global South. Our strength lies in creating dairy-like, complete nutrition at scale – thousands of tons – at a price point that ensures accessibility,” Worker confirms.
Our unique capability is developing dairy-like complete nutrition solutions that can achieve scale at an everyday price-point
Worker is speaking to us not from his New Zealand home but from Lisbon, where, he reveals, “we are currently setting up operations for scale-up production based in Portugal. Like New Zealand, Portugal is a global leader in marine science, and we want to be closer to our JDA customers as we move from producing kilograms to hundreds of kilograms of Marine Whey this year. We have recently been selected as a member of Portugal’s Unicorn Factory Scale Up program and UAE’s Mohammed Bin Rashid Innovation Fund, and have commercial partnerships underway across EMEA, Latin America and Asia”.

Brewing expertise
“The value proposition of our B2B ingredient, Fermotein, is about bringing improved nutrition without any organoleptic trade-offs, unlike most other plant proteins (typically, other plant proteins are not complete and bring undesired off-notes),” explains Samuel Claes, Commercial Director of Dutch startup, The Protein Brewery. “Improved nutrition means a one-stop shop ingredient that brings a complete protein (with a PDCAAS score of 1) in combination with fiber, vitamins and minerals, and no carbs,” Claes adds. “On top of that, we’ve selected a robust fermentation process that is unique in its design in such a way that it’s very cost-efficient and therefore easy to scale (both OPEX and CAPEX are much lower than competing technologies).”

Claes reports value on a couple of fronts from participating in the Growth Hack. “First, it allowed us to broaden our visibility to MISTA’s corporate partners. Next, we had the opportunity to work with them, gain first-hand feedback on the performance of our material, and could directly learn from the wealth of their experience. As many of MISTA’s partners are potential customers for us, we were able to become more visible and develop prototypes to meet their needs.”
Trial period
At the presentation event in San Francisco, The Protein Brewery was able to pitch to an audience of customers, investors, NGOs and research partners. On this, Claes comments, “We were able to connect closely with a few potential customers and one of those will now begin a trial of our material at MISTA’s lab facilities. MISTA is really able to bring together all players that are necessary to accelerate development.”
We’ve selected a unique and robust fermentation process that is very cost-efficient and therefore easy to scale
Claes is now busy on his own in-house development, reporting that, “We are executing our innovation pipeline: next to a finely milled version and an extruded version of Fermotein, we are also trying to extract the protein to come up with a neutral and complete protein isolate for which there is a very clear opportunity space in dairy alternatives and beverages. We also plan on starting some in vivo and in vitro trials to study the eventual health benefits of our material (hoping to see an eventual positive effect on the microbiome, and on GLP-1).”

Rich texture
Describing his unique position among the MISTA Growth Hack cohort, Cedric Verstraeten, CEO of Revyve, says, “We are the one biomass fermentation company that does not do fermentation! Our focus and knowhow is in downstream processing. Currently we use commercially available yeast as our feedstock. In our process we use simple mechanical processing to produce highly functional yeast proteins that are used to create texture in food products, replacing eggs or additives.”

Revyve’s process means that its ingredients have highly sought-after functional properties for those in the plant-based proteins food industry, such as benefits in terms of foaming, gelation, emulsification, and more. Its approach is also extremely efficient. “As we do not need to build expensive fermentation capacity to scale – and do not have regulatory constraints – we were able to scale in record time and are already producing at industrial scale with very good unit economics,” Verstraeten details.
Record time is a recurring theme for the Dutch startup and its participation at the Growth Hack was no different, as Verstraeten reveals in more detail. “The one-week event allowed us to make really fast progress on prototypes for applications that were new to us,” he says. “Having the experts of Bühler Group, Givaudan, AAK and Ingredion in the same kitchen as us for a full week was an incredible experience. Not only could we tap into a wealth of experience, but we could also work with their ingredients and identify synergies and benefits at a speed that would be unthinkable in a normal setup.” He also notes commercial benefits, commenting that, “It gave us the opportunity to convince the corporate team of the unique functionalities of our ingredients. Those connections laid the foundation for senior-level discussions and collaborations with those partners.”
Texturization technologies
The team at Revyve call themselves ‘texturologists’ and that descriptor nicely showcases why the firm’s ingredients product portfolio is an attractive proposition for the wide range of food companies looking to replace eggs or additives. Although taste and performance technologies are constantly evolving, texturization is one area where the new consumer demands for natural, clean-label, nutritious, animal-free food products have made progress somewhat challenging.
We are the one biomass fermentation company that does not do fermentation!
Verstraeten firmly believes that his ingredients can change that. “With our plant becoming fully operational at the end of 2024, we are really focused on making yeast protein the ‘go-to’ texturizing ingredient for the food industry.” And he reports excellent progress on the steps require to make this happen. “We’ve already had several large customers launch products with our ingredients in January and February 2025, and we’ve also announced a significant partnership with Lallemand to enter the North American market.
“The North American market is ripe for clean-label, sustainable solutions, and we expect strong adoption – especially in the plant-based and allergen-free segments,“ Verstraeten predicts. “Many US brands are actively seeking egg alternatives due to cost volatility, food safety concerns, and the growing demand for simple, recognizable ingredients.“

Nobody does it better
“We got a lot of value from participating in the Growth Hack,” states Doni C. Allen, Executive Vice President of Business Operations at The Better Meat Co. “Besides meeting incredible scientists in the biomass fermentation community, we were connected to important ingredient partners with whom our partnership continues to grow. For example, we’re currently working with AAK’s fat systems and Givaudan’s flavor systems to develop new applications using our Rhiza mycoprotein.”

The Better Meat Co. is a USA-headquartered B2B ingredients supplier offering solutions to both animal meat companies and alternative meat companies that are seeking to improve the nutritional profile of their products, all while cutting costs. “With this model, we’re also able to supply other mycelium-based companies,” notes Allen.
The company has rapidly become a leading player in manufacturing mycoproteins via whole biomass fungi fermentation. “We have invented efficient new methods of mycoprotein production, built and continuously operated a 9,000-liter fermentation system, earned five patents on our technology, and obtained FDA and USDA approval (GRAS),” says Allen proudly. “Rhiza mycoprotein is the first and only mycoprotein approved as safe and suitable by the USDA for inclusion in meat products,” she also points out.
Fabulous fungi
Detailing this flagship product, Allen describes Rhiza as “a protein-packed whole food ingredient made from filamentous fungi with a protein digestibility (PDCAAS) score of 0.87-0.96, which is close to animal proteins such as casein and egg”. On a dry weight basis, it contains 45-53% protein and 30% fiber. “Rhiza is shipped at ambient temperatures, and it hydrates instantly, unlike textured vegetable protein (TVP), and has a higher water- and oil-holding capacity. Our biggest use case is as an enhancer for animal meat. By adding Rhiza you can improve yield, add nutrition such as fiber, and lower calories, fat and sodium,” Allen explains.
We have invented efficient new methods of mycoprotein production
As with many companies in the biomass fermentation sector, the next issue that The Better Meat Co. is focusing on is that of scale. “We’re working on scaling up to commercially supply Rhiza – and we hope to have more news on this front shortly,” Allen hints.

Intelligent input
Representing a quite literal application of the concept ‘waste to energy’ is Bosco Emparanza García and his team at MOA Foodtech, which grows yeast strains that can feed off an assortment of food side streams – from distillers’ grains to crop residues – to add nutrition and functionality to a variety of foods.

“Our key differentiator is the combination of biotechnology and artificial intelligence (AI) to transform agro-industrial byproducts into high-value ingredients, reducing costs without compromising quality,” explains Emparanza. “There are many players in the industry that produce thousands of tons a year of byproducts and they are looking for new solutions. With our AI platform, Albatross, we optimize fermentation in real-time, maximizing efficiency and scalability. We don’t just create sustainable solutions – we make them viable and accessible for the industry.”
That latter point is not just talk: Emparanza proudly details that, “we have already created a database of more than 200 by-products that can be used as a substrate for fermentation, which allows us to significantly reduce the costs of the culture media we develop”.
Industrial revolution
The Spanish firm, which was founded in 2021 by Susana Sánchez, José María Elorza, and Emparanza in Pamplona, has already successfully scaled its first process to an industrial level, significantly lowering production costs and paving the way for broader commercial applications. In addition to this achievement, the company is actively working on expanding its technology. “We are also scaling up new processes based on cereal by-products,” reveals Emparanza. “These scaleups are food-grade, and we have no regulatory restrictions as novel food. As for our first ingredient, we are introducing it among several applications in extruded products, both in dry and wet extrusion. The differential impact is in functionality, taste, and nutrition,” he notes.
Our key differentiator is the combination of biotechnology and AI to transform byproducts into high-value ingredients
Emparanza, who also recently celebrated a €14.8 million investment commitment from the European Innovation Council, describes the Growth Hack as a unique and valuable opportunity. “It was a fantastic meeting point between the most advanced startups in the biomass sector and leading corporates interested in biomass fermentation,” he comments. “For us, it was the ideal medium to generate contacts and advance the relationships with some of the corporates.”

Emission possible
One of the most valuable case studies showcasing the benefits of the Growth Hack can be found at Greek microalgae-based ingredients expert, Solmeyea. Describing the firm’s selection for the event as “a pivotal moment”, Harshni Selvaraj, Head of Downstream, says it could not have come at a better time.
“We have been in constant communication and brainstorming trials with Danone since 2023,” Selvaraj reveals. “Our main focus has always been to join forces, thanks to our innovative, sustainable, and carbon-negative white microalgae protein, branded as MEY. Danone’s interest in our product led to our inclusion in the MISTA Growth Hack, which has proven to be an incredible opportunity to collaborate with leading food conglomerates and a well-deserved vote of confidence in the quality of our work, our plans, and our anticipated growth trajectory.”
The symposium gave experts a chance to explore MEY’s potential in various applications. “One highlight was prototyping the world’s first clean-label microalgae yogurt—high in protein and a sustainable alternative to animal-based and crop-based dairy substitutes,” says Selvaraj. She also emphasizes MEY’s positive environmental impact, noting that “it drastically reduces the carbon footprint compared to conventionally produced and imported ingredients.”
A second product prototype came in the form of a vegan brownie using MEY as a complete egg replacer, in collaboration with AAK and Ingredion. On this, Selveraj comments, “Experts in the field were impressed with the taste, and MEY successfully replaced two whole eggs without compromising flavor or texture.”
Selveraj says that, in the broader biomass fermentation industry, Solmeyea stands out due to its ability to produce industrial-scale, non-GMO, GRAS, EFSA & FDA-approved food-grade ingredients directly derived from its proprietary microalgae strains/cultures, via its intensified and IP-protected fermentation process. “These proteins are suitable for human consumption in both Europe and the USA, offering a promising and potentially game-changing alternative to traditional ingredients,” she states.
These proteins offer a promising and potentially game-changing alternative to traditional ingredients
“What truly sets our process apart is its innovation in utilizing CO2 emissions as a resource, resulting in the lowest environmental impact in terms of carbon, water, and land use. By efficiently converting CO2 into high-quality proteins, we address two critical global challenges: climate change, and food and natural resource scarcity. Our technology efficiently converts 6kg of CO2 into 1kg of protein. Even when accounting for emissions related to our production process, such as electricity usage, the overall carbon footprint remains negative. In fact, for every kilogram of MEY protein produced, we capture and utilize 2.5kg of CO2, making us the first company to effectively reduce greenhouse gas emissions while already producing market-ready food ingredients, ready for direct implementation and consumption by mass-market food manufacturers globally.”
MEY on the fast track to market
Things are moving quickly on the commercialization front. Since 2022, Solmeyea has been running its own biotech labs, a 1,200m2 production line, and offices within Greece’s NCSR Demokritos research campus. “Our production capacity is 30 tons of MEY proteins per year. We have established strategic partnerships with over 50 international food companies and multinational CPG brands in the EU and USA,” reveals Selvaraj. “So far, we have validated a range of food prototypes with our partners, including plant-based yogurts, cheese, steak, and tuna. We are also in discussions with several CPG multinationals looking to implement and launch new carbon-neutral – if not carbon-negative – products using MEY proteins by the end of 2025. Due to strong industry interest, we are fundraising and preparing for our industrial-scale flagship facility, expected to be ready by 2027.”

Cultivating expertise
When asked how his company stands out in the biomass fermentation sector, Aviel Even, CEO & Co-founder of Israeli company, Ingrediome, says that his technology differentiates itself via two groundbreaking innovations. “Firstly, we are the only company leveraging cyanobacteria [a group of aquatic and photosynthetic bacteria] for precision fermentation, a breakthrough that cuts fermentation CAPEX by more than 99% compared with conventional yeast or fungal-based systems.”

Directly utilizing CO2 and sunlight with agricultural feedstocks enables Ingrediome to eliminate costly inputs, dramatically reducing production costs while enabling rapid scalability and global deployment, even in arid or non-arable regions. “Leveraging commercially proven algae farming methods – already widely used in the food industry – allows us to rapidly scale production and commercialize within months, enabling faster market entry and cost-efficient scaling,” Even comments.
“Our second differentiator is in nature-identical meat proteins,” continues Even. “Ingrediome is the first to identify the key proteins responsible for the true culinary experience of meat. Rather than approximating texture or flavor with plant-based or engineered proteins, we produce genuine muscle proteins, ensuring authentic taste, texture, and performance in cooking. This revolutionizes meat production by enabling a sustainable, scalable alternative that is indistinguishable from conventional meat, without the environmental and ethical costs of livestock farming.”
Future focus
Ultimately, Even explains, “by combining low-cost, CO2-negative fermentation with precise meat protein replication, we are not just competing in the alternative protein space – we are fundamentally redefining the future of meat”.
Even and his team are currently focused on submitting their GRAS dossier and on increasing production to 200,000 liters at two locations next to the Dead Sea, which he describes as “an unprecedented scale for a company at seed stage”. This is partly to enable Ingrediome to meet its first commercial agreements with a deli meat producer, targeted for 2027.
This focus on what’s over the horizon is reflected in Even’s thoughts on the Growth Hack, which he says was valuable both from a technical and a commercial perspective. “We established high-impact industry connections with Givaudan, AAK, and Ingredion, strengthening our network within the food innovation ecosystem. With the guidance of program partners and access to their high-quality ingredients, we improved our product and refined our product-market fit, positioning our nature-identical meat for commercial success,” he explains. “Additionally, we received critical technology and production insights that helped us optimize our scaling strategy and product development. These refinements will enhance our production efficiency and accelerate our market entry.”
We are not just competing in the alternative protein space – we are fundamentally redefining the future of meat
Looking even further ahead, Even adds, “We also initiated promising discussions with food companies interested in incorporating our meat into their product lines. These conversations lay the groundwork for potential commercial agreements and co-development projects, further advancing our path to commercialization.”

Shine bright
“The MISTA symposium was highly valuable in fostering and illustrating how very real and rapid product development and collaboration between ourselves and multiple diverse large corporates could be possible,” believes Julian Melchiorri, Co-Founder & CEO of Arborea. “For example, we developed a delicious, ultra-sustainable plant-based alternative to milk with flavors from Givaudan, fats from AAK, functional ingredients from Ingredion with a brand-new package designed from scratch by SIG all brought together by Danone and in under a month from start to finish!”

Melchiorri also says the Growth Hack allowed Arborea to “hear, see and taste products from a diverse range of startups and technologies from different regions of the world as well as getting valuable insights from organizations such as Accenture and The Good Food Institute”.
And, he mentions, “It allowed us to use the MISTA facilities and experience how a European company could use them as a very convenient base for development work in the USA”.
That last point is interesting as it highlights how Arborea – which currently has sites in Portugal and the UK – is already visualizing the rollout of its technology on the global stage. On this, Melchiorri comments, “Arborea is unique in that our technology is both highly scalable and versatile, so it can be implemented quickly, without large CAPEX, anywhere the world needs it – which means a real impact can be made very quickly.”
Carbon capture scheme
Detailing the technology, Melchiorri says, “We can capture CO2 from any industrial process and convert it into food without needing any farmland. The CO2 does not need to be concentrated or pressurized and we are using natural sunlight as energy, so there are none of the costs normally associated with pressure vessels, fermentation tanks, feed-stocks, etc. The same equipment can be used to make up to 30,000 different varieties of photosynthetic microalgae although we have chosen to start with just one, spirulina. We can make proteins, colors, nutritional extracts all from the same source and the ingredients are all highly functional and versatile in themselves so can be used directly in a wide range of food and feed products.”
Melchiorri’s business model will see Arborea use its photosynthetic platform to provide truly sustainable proteins that are colorless, with a neutral taste, and at what he describes as an ‘unbeatable’ cost-in-use. “We can supply our ingredients to any food producing company seeking highly functional proteins that are cost effective, safe, scalable and carbon-neutral,” he confirms.
Our technology is both highly scalable and versatile, so can be implemented quickly, without large CAPEX, anywhere the world needs it
In terms of specific projects that illustrate the application of his innovative technology, Melchiorri cites three recent examples. “Current collaborative projects with partners involve replacing animal-based proteins such as egg white and whole egg in bakery applications; providing binding and gelling properties in alternative meat products to replace synthetic or not clean ingredients; and increasing protein content and ensuring nutritional balance in dairy products.”
Melchiorri’s focus is now on production. “We are breaking ground later this year and anticipate a profitable factory in full production (in partnership with our corporate partners) by the end of 2026. This factory serves as a blueprint for expansion anywhere in the world as it is both modular and scalable and uses CO2 and sunlight that are available everywhere,” Melchiorri states.

Future forecast
For Juan Manuel Benitez Garcia, Chief Commercial Officer of Finnish company Solar Foods, the Growth Hack came at the perfect time. “It was an ideal opportunity to show key US stakeholders Solein’s nutritional properties, taste and functionality in health and performance applications, while collaborating with key ingredient suppliers, flavor houses and F&B companies, such as Givaudan, Ingredion, AAK and Danone,” he explains.

Solein is the single-cell protein that Solar Foods produces out of thin air. To make it, the company generates hydrogen by using electricity to split water. And in that electrolysis process, the electrical energy is charged in the chemical form in hydrogen. This hydrogen and CO2 is fed into a fermenter with the company’s microbial culture. The microbes are hydrogen-oxidizing – meaning they eat hydrogen for energy instead of using sunlight or eating sugars. Solein is the resulting organism that grows on this cold gas fermentation basis.
Sustainable, single-cell solution
Describing how far the technology has already come, Benitez Garcia says, “We have a proven technology that is regulatory approved, has been scaled up to commercial level and offers great nutrition, taste and functionality, while being the most sustainable protein in the market. We are focusing on health and performance categories, working together with key brands in this space to bring Solein-based products to consumers in the US market.”
We have a proven technology that is regulatory approved, has been scaled up to commercial level and offers great nutrition, taste and functionality
In pursuit of that US market, Benitez Garcia explains that Solar Foods is now focusing on “supporting our customers in developing the most nutritional and tasteful experiences, while expanding the awareness of our product and market reach. The MISTA Growth Hack proved to be an important tool to assist us in both of those goals.”

Flour power
Biotech expert and entrepreneur Dr Monica Bhatia, Co-Founder & Co-CEO of EQUII, is using fermentation to produce high-protein grain flours that enhance the nutrition of staples such as bread and pasta. She says EQUII is the first complete protein technology to integrate with flour, highlighting its vast market potential. “Flour is the world’s top ingredient, a US$1 trillion market,” she notes. “Enhancing it with complete protein offers an immediate global nutrition solution.”

Bhatia says the firm’s biggest breakthrough is aligning protein with flour to maintain its taste and texture while delivering six times more bioavailable protein. She highlights its competitive edge in fermentation. “We’re very affordable – already at price parity with whey and cheaper than eggs and chickpeas.”.
Microbial magic
EQUII ferments wheat, oats, and rice with baker’s yeast, breaking down some carbs to release sugars that microbes convert into protein while preserving native grain proteins. The result is lower-carb, high-protein flours, already sold under EQUII’s brand as protein-rich bread, pasta, and a home baking kit.
Bhatia says the focus is now on scaling up. “We’re partnering with global brands to bring EQUII protein into popular foods such as bread, bakery, and pasta. In the USA, retail traction is growing, and in the coming months, we aim to scale strategically, ensuring financial returns for retailers and the brand while securing repeat consumers.”
We are very affordable relative to other fermented proteins: we’ve achieved price parity with whey, and are cheaper than eggs and chickpeas
It’s no surprise, then, that a major food sector event in the USA proved highly successful for EQUII, given the growing interest in innovative protein solutions. “At the Growth Hack, I connected with multiple partners eager to explore our ingredient for portfolio enhancement,” Bhatia shares. She also hints at promising developments on the horizon. “I am already planning testing with two of these entities, and I am hopeful that we will soon secure a valuable collaboration that will help drive wider adoption of our technology.”
California goals
California Cultured’s homepage boldly states its mission, ‘We are not an alternative to chocolate and coffee… we are the future.‘ For the team, that future lies in fermentation. The company grows cacao plant cells in bioreactors, feeding them sugars, vitamins, and minerals. The cells are then harvested, fermented, dried, and roasted to create cocoa powder.

The benefits of this approach – bypassing traditional farming – are clear, though it’s more commonly applied to meat rather than plants. “Plant-based biomass generation with ultra-efficient reactor technology lets us produce high-value ingredients that outperform traditional sources,” says CEO Alan Perlstein. “We are among the first to scale plant cell culture for food ingredients at an industrial level,” He notes plant cell-cultured ingredients have a higher consumer acceptance compared to biomass fermentation. “We can also produce flavors, textures, and bioactives simultaneously,” he adds.
With cocoa prices soaring, it’s no surprise that California Cultured is attracting interest from investors and the food industry. In late 2024, it secured a “significant” investment from Sparkalis, the food-tech arm of The Puratos Group, a major player in bakery, patisserie, and chocolate.
Scaling up for sweet success
The company also signed a 10-year commercial deal with Japan’s largest chocolate maker, Meiji, which will use its cell-cultured cocoa powder in confectionery and wellness products. To support this growth, Perlstein shares a major milestone: “We just held the ribbon-cutting for our new 12,000ft2 headquarters and labs in West Sacramento. In Q2, we’ll submit our GRAS dossier for product launch.”
We are among the first to scale plant cell culture for food ingredients at an industrial level
R&D is also expanding, partly inspired by the Growth Hack event. “It was extremely valuable,” Perlstein says. “Working with top formulation scientists let us explore new applications. We loved collaborating with partners such as Givaudan, AAK, and Danone. MISTA continues to be a great resource, helping us connect with major corporations.”

Naturally brewed
“We are honored to be a member of the MISTA ecosystem,” begins Julie Post-Smith, Chief-Commercial at Superbrewed Food. “The Growth Hack symposium significantly enhanced our connections with new potential partners and offered a valuable platform for collaborating with existing partners to advance key projects.”

Through the event, the company found new opportunities for its Postbiotic Cultured Protein in beverages, which it aims to develop in the coming months. “Our discussions strengthened ties with a global brand owner, advancing progress and showcasing commercial benefits,” Post-Smith says. “The Growth Hack provided valuable connections and insights to fuel long-term innovation.”
When asked how Superbrewed Foods differentiates itself in biomass fermentation, Post-Smith highlights its ability to “harness nature’s brilliance without overengineering it.” Rather than altering what nature has perfected, she explains, “we create the ideal environment to maximize its potential, producing the best complete protein for human nutrition”.
Fresh and clean
Detailing the product, Post-Smith notes, “Our technology uses non-GMO anaerobic fermentation to create a highly nutritious protein through a clean, scalable, and cost-effective process. This improves nutritional labels and unlocks new formulation possibilities for F&B.”
Expanding on that, Post-Smith explains, “Food formulators have traditionally relied on plant- or dairy-based proteins. While many protein sources exist, none fully meet key consumer and formulator needs—sustainability, non-GMO status, balanced nutrition, taste, color, and functionality.”
Instead of modifying what nature has already perfected, we create the ideal environment to optimize its potential
Superbrewed Foods is advancing the commercialization of Postbiotic Cultured Protein by expanding partnerships, scaling production, and raising its Series B funding. “We’re also conducting clinical studies to showcase its nutritional and functional benefits,” Post-Smith says. “We’re excited about our next growth phase and the impact our technology will have on sustainable nutrition.”

Up in the air
One of the big names in proteins produced via gas fermentation is Calysta, a USA-headquartered firm with an industrial-scale fermentation facility in China. “Calysta stands out due to our scale of production,” believes Dr Lori Giver, Chief Scientific & Sustainability Officer. “We have an operating commercial fermenter that produced thousands of tons last year.”

The company’s primary products are FeedKind Pet and FeedKind Aqua, respectively targeted at pet-food companies and aquaculture feed producers, but Giver points out that, “we can use that same production platform for food ingredients. The ability to jump straight to commercial volumes is a real differentiator for us”.
Calysta’s biomass is produced without agricultural land via a proprietary gas fermentation process. “Its high protein content (68%) and balanced amino acid profile make it easy to use across the food and feed value chain. We also see interesting benefits around emulsifying and binding fats,” Giver details.
Delicious discoveries
The Calysta team took advantage of the MISTA Growth Hack to explore some of those potential applications. “We were able to work with companies making binders, fats, and starches to produce crackers and plant-based burgers that were great proofs of concept. It let us feature our protein in some great-tasting products,” Giver reveals. “The symposium was a great opportunity for companies such as ours to connect to other ingredient producers, flavor and processing experts such as Givaudan or Ingredion, and consumer-facing brands.”
The ability to jump straight to commercial volumes is a real differentiator for us
When asked what Calysta will be working on next, Giver says the company has an exciting year ahead. “We’ll be continuing to ramp production in China toward a nameplate of 20,000 tons per year, expand our international sales, and see a variety of new pet foods launch featuring FeedKind Pet protein,” she confirms.

Mushroom magic
According to Nirmal Nair, CEO & Founder of Sempera Organics, 2025 looks promising for fungi-based functional ingredients in food. Nair reports progress on multiple fronts. “We are scaling from our first pilot facility to meet demand and proving the next stage of our bio-refinery model. Two clinical trials on brain and gut health are underway. We expect to announce new developments in Q2, so stay tuned,” he hints.

The flagship product from Sempera Organics is called ‘Mamu’, which is an alt meat that it produces by fermenting chickpeas with mushroom mycelium in a low-cost, solid-state, zero-waste fermentation process conducted in plastic bags instead of expensive bioreactors. That low-cost process is interesting, but Nair is keen to point out that it’s far from the only differentiator here.
“We are focused on solid-state fermentation technology to create sustainable solutions for functional ingredients,” he says. “This is a different approach from the liquid fermentation process used by some other players in the space. We have developed a scale out (versus scale up) process that allows for low CAPEX and a flexible OPEX approach to commercialization, as evidenced by our market traction.”
Strategic showcase
Further traction was encouraged via Sempera Organics’ participation in the Growth Hack. “It gave us the opportunity to showcase our science and technology to a focused audience within our ecosystem,” Nair reports. “It allowed us to present our unique solutions in a space filled with highly competent companies, all setting out to solve hard problems in bio manufacturing with practical outcomes, so we are very thankful for that.”
We have developed a scale out (versus scale up) process that allows for low CAPEX and a flexible OPEX approach to commercialization
In terms of tangible benefits emerging from the event, Nair comments, “It was a great chance to collect feedback from the audience, many of whom could be potential strategic partners.“ Engaging with key stakeholders in such a focused setting allows for valuable discussions that could lead to long-term collaborations. “Some conversations have already begun, and we hope to continue those toward positive outcomes later this year.”
If you have any questions or would like to get in touch with us, please email info@futureofproteinproduction.com





